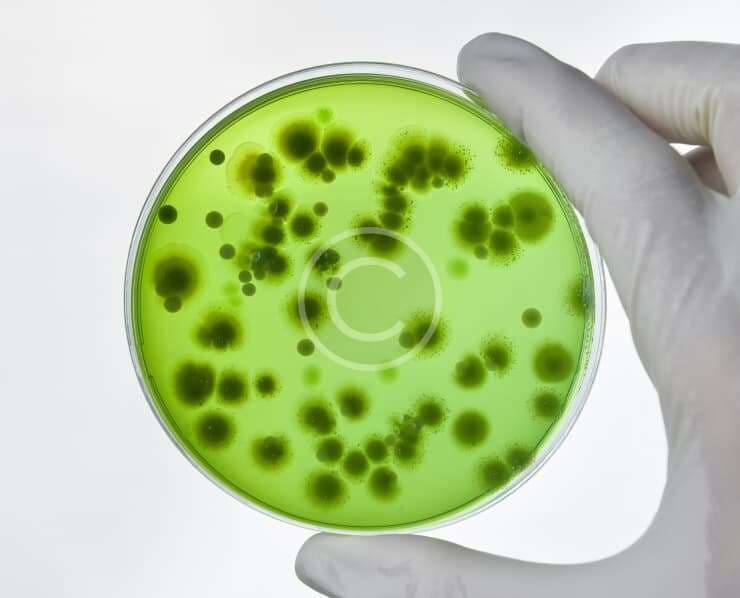
Laboratory Testing

How family involvement improves patient recovery rates
When a patient is admitted to the hospital, the focus often centers on medical treatment. But research consistently shows that family involvement plays a significant role in how quickly and effectively patients recover.